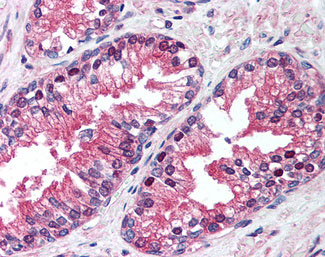

VCP Antibody (clone 4G9)
Mouse Monoclonal Antibody
- SPECIFICATION
- CITATIONS
- PROTOCOLS
- BACKGROUND

Application
| WB, IHC-P, IF, ICC, IP |
|---|---|
| Primary Accession | P55072 |
| Reactivity | Human |
| Host | Mouse |
| Clonality | Monoclonal |
| Clone Names | 4G9 |
| Calculated MW | 89kDa |
| Dilution | IHC-P (5 µg/ml) |
| Gene ID | 7415 |
|---|---|
| Other Names | Transitional endoplasmic reticulum ATPase, TER ATPase, 3.6.4.6, 15S Mg(2+)-ATPase p97 subunit, Valosin-containing protein, VCP, VCP |
| Target/Specificity | Recombinant human valosin containing protein |
| Reconstitution & Storage | Long term: -20°C; Short term: +4°C; Avoid freeze-thaw cycles. |
| Precautions | VCP Antibody (clone 4G9) is for research use only and not for use in diagnostic or therapeutic procedures. |
| Name | VCP |
|---|---|
| Function | Necessary for the fragmentation of Golgi stacks during mitosis and for their reassembly after mitosis. Involved in the formation of the transitional endoplasmic reticulum (tER). The transfer of membranes from the endoplasmic reticulum to the Golgi apparatus occurs via 50-70 nm transition vesicles which derive from part-rough, part-smooth transitional elements of the endoplasmic reticulum (tER). Vesicle budding from the tER is an ATP-dependent process. The ternary complex containing UFD1, VCP and NPLOC4 binds ubiquitinated proteins and is necessary for the export of misfolded proteins from the ER to the cytoplasm, where they are degraded by the proteasome. The NPLOC4- UFD1-VCP complex regulates spindle disassembly at the end of mitosis and is necessary for the formation of a closed nuclear envelope. Regulates E3 ubiquitin-protein ligase activity of RNF19A. Component of the VCP/p97-AMFR/gp78 complex that participates in the final step of the sterol-mediated ubiquitination and endoplasmic reticulum-associated degradation (ERAD) of HMGCR. Mediates the endoplasmic reticulum- associated degradation of CHRNA3 in cortical neurons as part of the STUB1-VCP-UBXN2A complex (PubMed:26265139). Involved in endoplasmic reticulum stress-induced pre-emptive quality control, a mechanism that selectively attenuates the translocation of newly synthesized proteins into the endoplasmic reticulum and reroutes them to the cytosol for proteasomal degradation (PubMed:26565908). Involved in clearance process by mediating G3BP1 extraction from stress granules (PubMed:29804830, PubMed:34739333). Also involved in DNA damage response: recruited to double-strand breaks (DSBs) sites in a RNF8- and RNF168-dependent manner and promotes the recruitment of TP53BP1 at DNA damage sites (PubMed:22020440, PubMed:22120668). Recruited to stalled replication forks by SPRTN: may act by mediating extraction of DNA polymerase eta (POLH) to prevent excessive translesion DNA synthesis and limit the incidence of mutations induced by DNA damage (PubMed:23042605, PubMed:23042607). Together with SPRTN metalloprotease, involved in the repair of covalent DNA-protein cross- links (DPCs) during DNA synthesis (PubMed:32152270). Involved in interstrand cross-link repair in response to replication stress by mediating unloading of the ubiquitinated CMG helicase complex (By similarity). Mediates extraction of PARP1 trapped to chromatin: recognizes and binds ubiquitinated PARP1 and promotes its removal (PubMed:35013556). Required for cytoplasmic retrotranslocation of stressed/damaged mitochondrial outer-membrane proteins and their subsequent proteasomal degradation (PubMed:16186510, PubMed:21118995). Essential for the maturation of ubiquitin-containing autophagosomes and the clearance of ubiquitinated protein by autophagy (PubMed:20104022, PubMed:27753622). Acts as a negative regulator of type I interferon production by interacting with RIGI: interaction takes place when RIGI is ubiquitinated via 'Lys-63'-linked ubiquitin on its CARD domains, leading to recruit RNF125 and promote ubiquitination and degradation of RIGI (PubMed:26471729). May play a role in the ubiquitin-dependent sorting of membrane proteins to lysosomes where they undergo degradation (PubMed:21822278). May more particularly play a role in caveolins sorting in cells (PubMed:21822278, PubMed:23335559). By controlling the steady-state expression of the IGF1R receptor, indirectly regulates the insulin-like growth factor receptor signaling pathway (PubMed:26692333). |
| Cellular Location | Cytoplasm, cytosol. Endoplasmic reticulum. Nucleus. Cytoplasm, Stress granule. Note=Present in the neuronal hyaline inclusion bodies specifically found in motor neurons from amyotrophic lateral sclerosis patients (PubMed:15456787). Present in the Lewy bodies specifically found in neurons from Parkinson disease patients (PubMed:15456787). Recruited to the cytoplasmic surface of the endoplasmic reticulum via interaction with AMFR/gp78 (PubMed:16168377) Following DNA double-strand breaks, recruited to the sites of damage (PubMed:22120668). Recruited to stalled replication forks via interaction with SPRTN (PubMed:23042605). Recruited to damaged lysosomes decorated with K48-linked ubiquitin chains (PubMed:27753622) Colocalizes with TIA1, ZFAND1 and G3BP1 in cytoplasmic stress granules (SGs) in response to arsenite-induced stress treatment (PubMed:29804830). |

Thousands of laboratories across the world have published research that depended on the performance of antibodies from Abcepta to advance their research. Check out links to articles that cite our products in major peer-reviewed journals, organized by research category.
info@abcepta.com, and receive a free "I Love Antibodies" mug.
Provided below are standard protocols that you may find useful for product applications.
Background
Necessary for the fragmentation of Golgi stacks during mitosis and for their reassembly after mitosis. Involved in the formation of the transitional endoplasmic reticulum (tER). The transfer of membranes from the endoplasmic reticulum to the Golgi apparatus occurs via 50-70 nm transition vesicles which derive from part-rough, part-smooth transitional elements of the endoplasmic reticulum (tER). Vesicle budding from the tER is an ATP-dependent process. The ternary complex containing UFD1L, VCP and NPLOC4 binds ubiquitinated proteins and is necessary for the export of misfolded proteins from the ER to the cytoplasm, where they are degraded by the proteasome. The NPLOC4-UFD1L-VCP complex regulates spindle disassembly at the end of mitosis and is necessary for the formation of a closed nuclear envelope. Regulates E3 ubiquitin-protein ligase activity of RNF19A. Component of the VCP/p97-AMFR/gp78 complex that participates in the final step of the sterol-mediated ubiquitination and endoplasmic reticulum-associated degradation (ERAD) of HMGCR. Also involved in DNA damage response: recruited to double-strand breaks (DSBs) sites in a RNF8- and RNF168-dependent manner and promotes the recruitment of TP53BP1 at DNA damage sites. Recruited to stalled replication forks by SPRTN: may act by mediating extraction of DNA polymerase eta (POLH) to prevent excessive translesion DNA synthesis and limit the incidence of mutations induced by DNA damage. Required for cytoplasmic retrotranslocation of stressed/damaged mitochondrial outer-membrane proteins and their subsequent proteasomal degradation.
References
Lamerdin J.E.,et al.Submitted (MAR-1998) to the EMBL/GenBank/DDBJ databases.
Hu R.-M.,et al.Proc. Natl. Acad. Sci. U.S.A. 97:9543-9548(2000).
Ota T.,et al.Nat. Genet. 36:40-45(2004).
Humphray S.J.,et al.Nature 429:369-374(2004).
Mural R.J.,et al.Submitted (SEP-2005) to the EMBL/GenBank/DDBJ databases.
If you have used an Abcepta product and would like to share how it has performed, please click on the "Submit Review" button and provide the requested information. Our staff will examine and post your review and contact you if needed.
If you have any additional inquiries please email technical services at tech@abcepta.com.





Foundational characteristics of cancer include proliferation, angiogenesis, migration, evasion of apoptosis, and cellular immortality. Find key markers for these cellular processes and antibodies to detect them.
The SUMOplot™ Analysis Program predicts and scores sumoylation sites in your protein. SUMOylation is a post-translational modification involved in various cellular processes, such as nuclear-cytosolic transport, transcriptional regulation, apoptosis, protein stability, response to stress, and progression through the cell cycle.
The Autophagy Receptor Motif Plotter predicts and scores autophagy receptor binding sites in your protein. Identifying proteins connected to this pathway is critical to understanding the role of autophagy in physiological as well as pathological processes such as development, differentiation, neurodegenerative diseases, stress, infection, and cancer.